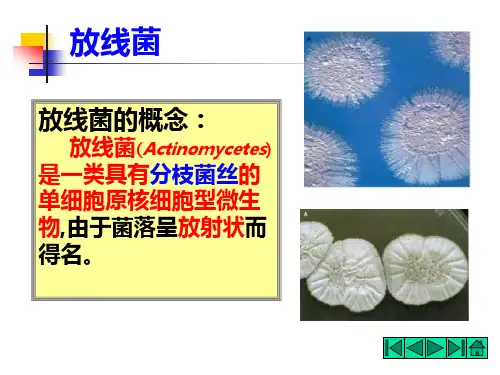

放线菌的介绍及与细菌的详细比较PPT课件
- 格式:ppt
- 大小:1011.50 KB
- 文档页数:12


放线菌和细菌的异同点
放线菌和细菌是两种不同的微生物,它们存在一些异同点。
相同点:
1. 都是原核生物:放线菌和细菌都属于原核生物,其细胞结构和基本功能与真核生物有很大区别。
2. 都是微生物:放线菌和细菌都是非常小的微生物,只能在显微镜下观察到。
3. 都可引起疾病:放线菌和某些细菌可以引起人类和其他生物的感染和疾病。
异同点:
1. 形态结构不同:细菌呈单细胞结构,其形态可以有球形、杆状、螺旋状等多种形式;放线菌多为链状菌体,由许多细胞组成。
2. 分子生物学特征不同:细菌的基因组较小,一般只有一个圆形染色体和一些质粒;而放线菌的基因组较大,常包含多个线形染色体。
3. 生理功能不同:细菌和放线菌的代谢功能存在差异。
放线菌能够产生多种抗生素等次级代谢产物,在土壤控制有害微生物方面具有重要作用。
细菌能够以各种不同方式进行代谢,例如一些细菌可以进行光合作用。
4. 耐受条件不同:放线菌通常对环境要求较高,对温度、湿度和营养物质等要求较为苛刻;而细菌在适宜的条件下可以在各种环境中生存和繁殖。
需要注意的是,放线菌和细菌种类繁多,存在着大量的亚种和
变种,因此以上的异同点仅仅是一般性的描述,具体情况还需要根据具体的菌种进行具体分析。